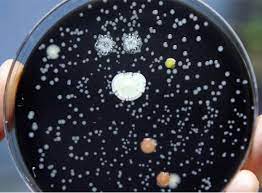
Top 7 Signs You Need Immediate Legionella Testing

Maintaining safe water systems isn’t just a legal obligation, it’s essential for protecting the health of everyone in your building. Legionella bacteria can grow quickly in poorly maintained or stagnant water, and if left unchecked, can cause Legionnaires’ disease, a potentially fatal form of pneumonia. That’s why legionella testing UK is crucial for commercial buildings, healthcare facilities, industrial sites, and large residential properties.
But how do you know when it’s time to schedule a test urgently? Here are the top 7 signs that indicate immediate legionella testing is needed.
1. Areas of Stagnant or Low-Use Water
Legionella thrives in stagnant water. If parts of your building are rarely used such as spare rooms, storage areas, or seasonal facilities water can sit in the pipes for days or weeks, creating ideal conditions for bacterial growth.
- Signs to watch for include:
- Unused taps or showers
- Dead legs in plumbing
- Water tanks without circulation
Alongside testing, closed system water treatment can help maintain safe water circulation and prevent bacterial growth over time.
2. Recent Water System Changes
Any alterations to your plumbing or water systems can increase the risk of contamination. Examples include:
- Pipe replacements or extensions
- Installation of new pumps, valves, or outlets
- Major renovations or building work
During such changes, debris and biofilm can enter the system. That’s why pre commission cleaning is essential before activating new or modified systems. Once the work is complete, legionella testing UK should be conducted to ensure the system is safe. Even installing water filtration systems can alter flow dynamics, requiring careful testing.
3. Inconsistent Hot and Cold Water Temperatures
Legionella multiplies most quickly between 20°C and 45°C. Fluctuating water temperatures can therefore encourage growth. Warning signs include:
- Hot water not reaching 50°C promptly
- Cold water feeling warm
- Inconsistent temperatures throughout the day
Such issues often point to problems like limescale buildup, sludge, or inefficiencies in boilers. Regular boiler descaling and closed system analysis can help maintain safe water temperatures and prevent bacterial colonisation.
4. Visible Sludge, Scale, or Corrosion
Water discoloration, sludge, and rust are clear indicators that your system might be contaminated. These conditions create surfaces where bacteria, including Legionella, can thrive.
- Problems associated with scale and corrosion:
- Reduced water flow
- Hot water inefficiency
- Damage to pumps and valves
Integrating closed system water treatment and regular flushing can prevent biofilm buildup, but any visible contamination should trigger immediate testing.
5. Extended Building Closures or Low Occupancy
Buildings that remain unused for long periods such as offices during holidays or seasonal facilities are particularly vulnerable to Legionella. During inactivity, water stagnates, increasing bacterial growth risks.
- Action steps when reopening:
- Full water hygiene inspection
- Flushing all taps and outlets
- Immediate legionella testing UK
Even partially occupied or hybrid workplaces should maintain water flow and testing schedules to avoid risk.
6. Complaints About Water Quality or Smells
Strange tastes, cloudy water, or unusual odours can indicate microbial growth in your system. These may include:
- Musty or metallic smells
- Cloudy or foamy water
- Reports of warm water from cold taps
While not all bacteria are harmful, any change in water quality should be treated seriously. Immediate testing helps ensure safety, especially in settings like schools, hospitals, or care homes.
7. Chemical Imbalances or Poor Maintenance
Water systems with HVAC pipework, chillers, or heating loops rely on chemical balance to prevent bacterial growth. Warning signs include:
- Low inhibitor levels
- Improper glycol concentrations in chilled systems
- Evidence of corrosion or biofilm formation
Regular glycol testing, closed system analysis, and maintenance checks are essential. If chemical levels are off, scheduling legionella testing UK is critical to prevent contamination.
Why Immediate Legionella Testing Matters
Legionnaires’ disease outbreaks can damage reputations, harm health, and lead to legal consequences. Early detection and treatment prevent:
- System contamination
- Health risks to occupants
- Costly emergency cleaning or replacements
Combining testing with preventive measures such as closed system water treatment, boiler descaling, pre commission cleaning, and installing water filtration systems ensures long-term safety and compliance.
Final Thoughts
If you notice any of the seven warning signs, don’t delay. Legionella can multiply rapidly, and early detection is the most effective defence. By implementing both regular legionella testing UK and ongoing water system maintenance, you protect both your building and its occupants.
Remember: prevention is always better than cure. Schedule testing today and maintain a safe, compliant water system for the future.


















